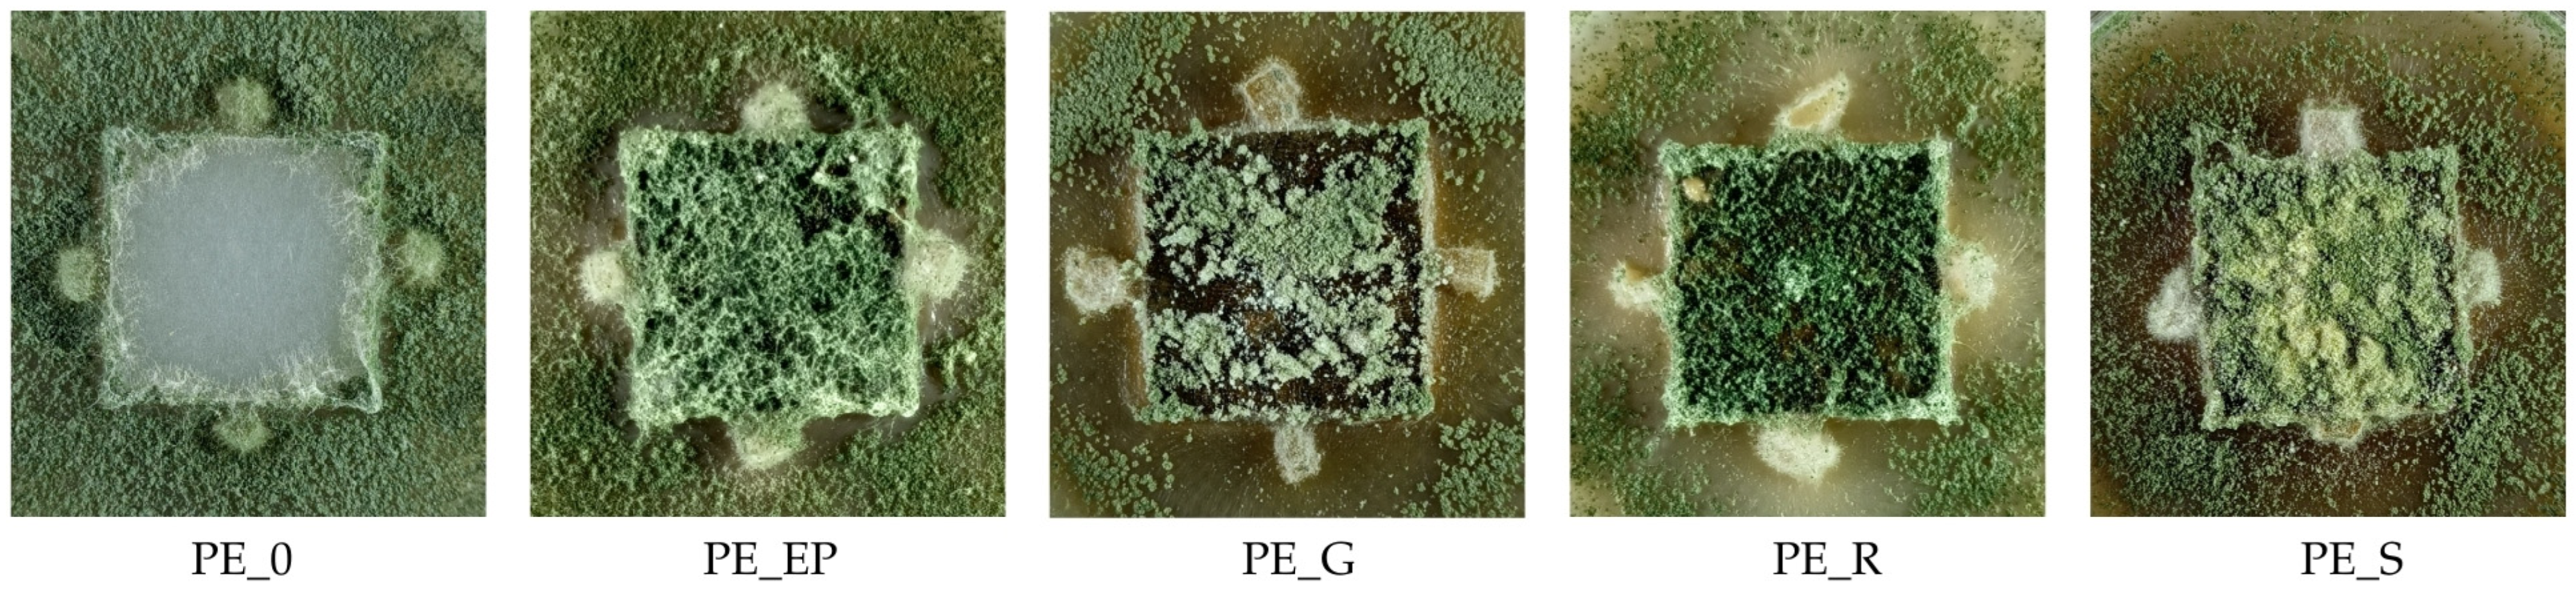
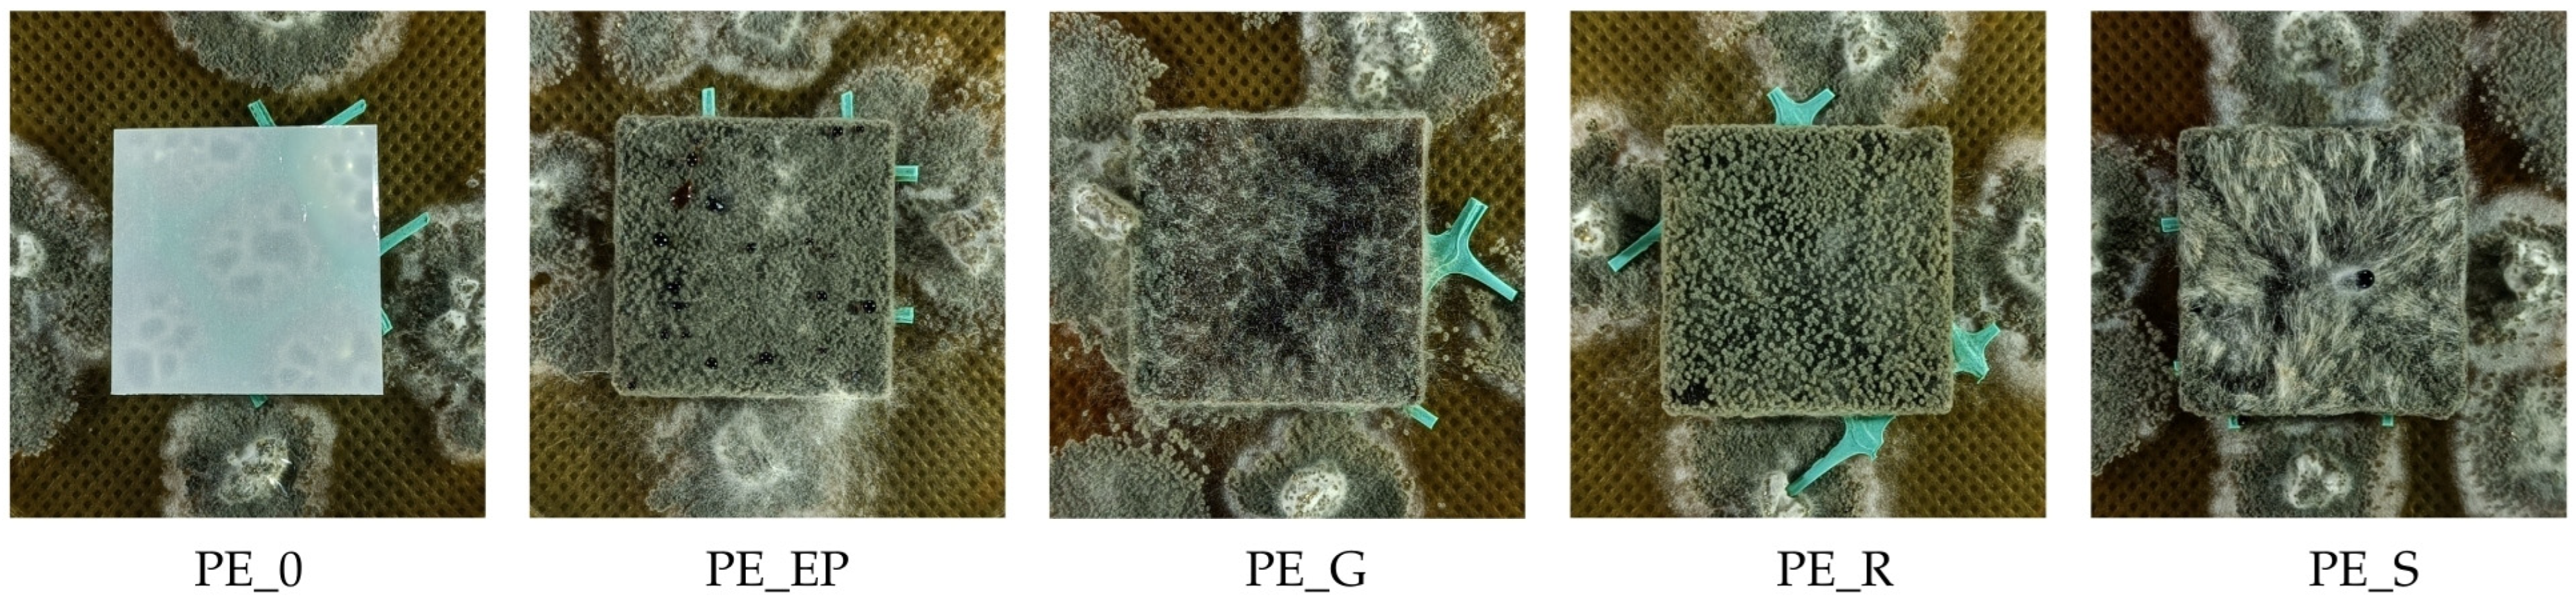

Oil Plant Pomace as a Raw Material in Technology of Sustainable Thermoplastic Polymer Composites
Abstract
1. Introduction
2. Materials and Methods
2.1. Preparation of Biocomposites
- PE_0: pure high-density polyethylene (HDPE) or control samples;
- PE_EP: HDPE + evening primrose seed pomace;
- PE_G: HDPE + gold of pleasure seed pomace;
- PE_R: HDPE + rapeseed seed pomace;
- PE_S: HDPE + sunflower seed pomace.
2.2. Quality Parameters of Composites
2.2.1. Density and Mechanical Properties
2.2.2. Surface Roughness
2.2.3. Contact Angle
2.2.4. Water Absorption and Thickness Swelling
2.2.5. Fourier-Transform Infrared Spectroscopy (FTIR)
2.2.6. Thermal Properties of Composites
2.2.7. SEM Analysis
2.2.8. Growth of Fungi
2.3. Test Standards
3. Results and Discussion
3.1. Density and Mechanical Properties
3.2. Surface Roughness
3.3. Contact Angle
3.4. Water Absorption and Thickness Swelling
3.5. Fourier-Transform Infrared Spectroscopy (FTIR)
- EP_0: evening primrose seed pomace;
- G_0: gold of pleasure seed pomace;
- R_0: rapeseed seed pomace;
- S_0: sunflower seed pomace.
3.6. Thermal Properties of Composites
3.7. SEM Analysis
3.8. Growth of Fungi
4. Conclusions
Author Contributions
Funding
Institutional Review Board Statement
Informed Consent Statement
Data Availability Statement
Acknowledgments
Conflicts of Interest
References
- Lopez Barrera, E.; Hertel, T. Global Food Waste across the Income Spectrum: Implications for Food Prices, Production and Resource Use. Food Policy 2021, 98, 101874. [Google Scholar] [CrossRef]
- Vastola, A.; Viccaro, M.; Grippo, V.; Genovese, F.; Romano, S.; Cozzi, M. The Decoupling Effect in Italian Agricultural Waste: An Empirical Analysis. Sustainability 2023, 15, 16596. [Google Scholar] [CrossRef]
- Onu-Okpara, I.Q.; Oranusi, S.; Okagbue, H. Production of Probiotic-Fortified Composite Poultry Feed from Food and Agricultural Waste Material. J. Adv. Vet. Anim. Res. 2019, 6, 544–548. [Google Scholar] [CrossRef] [PubMed]
- Sugiura, K.; Yamatani, S.; Watahara, M.; Onodera, T. Ecofeed, animal feed produced from recycled food waste. Vet. Ital. 2009, 45, 397–404. [Google Scholar]
- Chiaraluce, G.; Bentivoglio, D.; Finco, A. The Circular Economy Model in the Agri Food Sector: A New Strategy for the Regional Development. AIMS Agric. Food 2023, 8, 851–872. [Google Scholar] [CrossRef]
- Dzepe, D.; Kuietche, H.M.; Magatsing, O.; Meutchieye, F.; Nana, P.; Tchuinkam, T.; Djouaka, R. From Agricultural Waste to Chicken Feed Using Insect-Based Technology. J. Basic Appl. Zool. 2023, 84, 18. [Google Scholar] [CrossRef]
- Barus, J.; Mustikawati, D.R.; Endriani; Meithasari, D.; Ernawati, R.; Wardani, N.; Soraya; Suretno, N.D.; Tambunan, R.D.; Silalahi, M. Evaluation of Composting of Several Plant Biomass Wastes with Different Types of Starters. Int. J. Recycl. Org. Waste Agric. 2023, 12, 503–514. [Google Scholar] [CrossRef]
- Panchami, P.S.; Gunasekaran, S. Extraction and Characterization of Pectin from Fruit Waste. Int. J. Curr. Microbiol. Appl. Sci. 2017, 6, 943–948. [Google Scholar] [CrossRef]
- Pourbafrani, M.; Forgács, G.; Horváth, I.S.; Niklasson, C.; Taherzadeh, M.J. Production of Biofuels, Limonene and Pectin from Citrus Wastes. Bioresour. Technol. 2010, 101, 4246–4250. [Google Scholar] [CrossRef]
- Ojewumi, M.E.; Emetere, M.E.; Amaefule, C.V.; Durodola, B.M.; Adeniyi, O.D. Bioconversion of orange peel waste by escherichia coli and saccharomyces cerevisiae to ethanol. Int. J. Pharm. Sci. Res. 2019, 10, 1246. [Google Scholar] [CrossRef]
- Perea-Moreno, M.A.; Manzano-Agugliaro, F.; Perea-Moreno, A.J. Sustainable Energy Based on Sunflower Seed Husk Boiler for Residential Buildings. Sustainability 2018, 10, 3407. [Google Scholar] [CrossRef]
- Grzelczyk, J.; Oracz, J.; Gałązka-Czarnecka, I. Quality Assessment of Waste from Olive Oil Production and Design of Biodegradable Packaging. Foods 2022, 11, 3776. [Google Scholar] [CrossRef] [PubMed]
- Mohanty, A.; Mankoti, M.; Rout, P.R.; Meena, S.S.; Dewan, S.; Kalia, B.; Varjani, S.; Wong, J.W.C.; Banu, J.R. Sustainable Utilization of Food Waste for Bioenergy Production: A Step towards Circular Bioeconomy. Int. J. Food Microbiol. 2022, 365, 109538. [Google Scholar] [CrossRef] [PubMed]
- Liu, H.; Chen, Y. Supporting Information Enhanced Methane Production from Food Waste Using Cysteine to Increase Biotransformation of L-Monosaccharide, VFA and Bio-Hydrogen. Environ. Sci. Technol. 2018, 52, 3777–3785. [Google Scholar] [CrossRef]
- Javourez, U.; O’Donohue, M.; Hamelin, L. Waste-to-Nutrition: A Review of Current and Emerging Conversion Pathways. Biotechnol. Adv. 2021, 53, 107857. [Google Scholar] [CrossRef]
- Raboanatahiry, N.; Li, H.; Yu, L.; Li, M. Rapeseed (Brassica napus): Processing, Utilization, and Genetic Improvement. Agronomy 2021, 11, 1776. [Google Scholar] [CrossRef]
- Khaksar, G.; Sirijan, M.; Suntichaikamolkul, N.; Sirikantaramas, S. Metabolomics for Agricultural Waste Valorization: Shifting Toward a Sustainable Bioeconomy. Front. Plant Sci. 2022, 13, 938480. [Google Scholar] [CrossRef]
- Esposito, T.; Paolucci, M.; Sansone, F.; Mencherini, T.; Pacifico, S.; Volpe, M.G. Exploitation and Valorization of Agro-Food Wastes from Grape Harvesting: Production, Characterization of Mae-Extracts from Vitis Vinifera Leaves and Stabilization in Microparticulate Powder Form. Appl. Sci. 2021, 11, 5827. [Google Scholar] [CrossRef]
- Rajendran, N.; Han, J. Integrated Polylactic Acid and Biodiesel Production from Food Waste: Process Synthesis and Economics. Bioresour. Technol. 2022, 343, 126119. [Google Scholar] [CrossRef] [PubMed]
- Balasuriya, P.W.; Ye, L.; Mai, Y.W.; Wu, J. Mechanical Properties of Wood Flake-Polyethylene Composites. II. Interface Modification. J. Appl. Polym. Sci. 2002, 83, 2505–2521. [Google Scholar] [CrossRef]
- Caton, P.A.; Carr, M.A.; Kim, S.S.; Beautyman, M.J. Energy Recovery from Waste Food by Combustion or Gasification with the Potential for Regenerative Dehydration: A Case Study. Energy Convers. Manag. 2010, 51, 1157–1169. [Google Scholar] [CrossRef]
- Johari, A.; Ahmed, S.I.; Hashim, H.; Alkali, H.; Ramli, M. Economic and Environmental Benefits of Landfill Gas from Municipal Solid Waste in Malaysia. Renew. Sustain. Energy Rev. 2012, 16, 2907–2912. [Google Scholar] [CrossRef]
- Mizielińska, M.; Lisiecki, S. Coating of Polylactide Films to Generate Their Antimicrobial Properties Powlekanie Folii Polilaktydowej w Celu Nadania Jej Właściwości Antymikrobowych. Przemysł Chem. 2015, 94, 752–755. [Google Scholar] [CrossRef]
- Takács, K.; Pregi, E.; Vági, E.; Renkecz, T.; Tátraaljai, D.; Pukánszky, B. Processing Stabilization of Polyethylene with Grape Peel Extract: Effect of Extraction Technology and Composition. Molecules 2023, 28, 1011. [Google Scholar] [CrossRef] [PubMed]
- Hafeez, M.A.; Maan, A.A.; Butt, M.S.; Zia, M.A. Development and Characterization of Biodegradable Food Packaging Films from Food Industrial Wastes. Pak. J. Agric. Sci. 2021, 58, 609–619. [Google Scholar] [CrossRef]
- Spiridon, I.; Ursu, R.G.; Spiridon, I.A.C. New Polylactic Acid Composites for Packaging Applications: Mechanical Properties, Thermal Behavior, and Antimicrobial Activity. Int. J. Polym. Anal. Charact. 2015, 20, 681–692. [Google Scholar] [CrossRef]
- Gowman, A.; Rodriguez-Uribe, A.; Defersha, F.; Mohanty, A.K.; Misra, M. Statistical Design of Sustainable Composites from Poly(Lactic Acid) and Grape Pomace. J. Appl. Polym. Sci. 2020, 137, 49061. [Google Scholar] [CrossRef]
- Bruna, J.E.; Castillo, M.; López de Dicastillo, C.; Muñoz-Shugulí, C.; Lira, M.; Guarda, A.; Rodríguez-Mercado, F.J.; Galotto, M.J. Development of Active Biocomposite Films Based on Poly(Lactic Acid) and Wine by-Product: Effect of Grape Pomace Content and Extrusion Temperature. J. Appl. Polym. Sci. 2023, 140, e54425. [Google Scholar] [CrossRef]
- Banat, R. Olive Pomace Flour as Potential Organic Filler in Composite Materials: A Brief Review. Am. J. Polym. Sci. 2019, 9, 10–15. [Google Scholar] [CrossRef]
- Oulidi, O.; Nakkabi, A.; Elaraaj, I.; Fahim, M.; Moualij, N. El Incorporation of Olive Pomace as a Natural Filler in to the PA6 Matrix: Effect on the Structure and Thermal Properties of Synthetic Polyamide 6. Chem. Eng. J. Adv. 2022, 12, 100399. [Google Scholar] [CrossRef]
- Luo, Z.; Li, P.; Cai, D.; Chen, Q.; Qin, P.; Tan, T.; Cao, H. Comparison of Performances of Corn Fiber Plastic Composites Made from Different Parts of Corn Stalk. Ind. Crops Prod. 2017, 95, 521–527. [Google Scholar] [CrossRef]
- Castrillón, H.D.C.; Aguilar, C.M.G.; Álvarez, B.E.A. Circular Economy Strategies: Use of Corn Waste to Develop Biomaterials. Sustainability 2021, 13, 8356. [Google Scholar] [CrossRef]
- Pratheep, V.G.; Priyanka, E.B.; Thangavel, S.; Gousanal, J.J.; Antony, P.T.B.; Kavin, E.D. Investigation and Analysis of Corn Cob, Coir Pith with Wood Plastic. Mater. Today-Proc. 2021, 45, 549–555. [Google Scholar] [CrossRef]
- Chong, T.Y.; Law, M.C.; Chan, Y.S. The Potentials of Corn Waste Lignocellulosic Fibre as an Improved Reinforced Bioplastic Composites. J. Polym. Environ. 2021, 29, 363–381. [Google Scholar] [CrossRef]
- Shen, T.; Li, M.; Zhang, B.; Zhong, L.; Lin, X.; Yang, P.; Li, M.; Zhuang, W.; Zhu Chenjie and Ying, H. Enhanced Mechanical Properties of Polyvinyl Chloride-Based Wood-Plastic With Pretreated Corn Stalk. Front. Bioeng. Biotechnol. 2022, 9, 829821. [Google Scholar] [CrossRef]
- Lipska, K.; Ufnowski, P. Corn Pomace as a Substitute for Wood Raw Material in Lignocellulosiccomposite Technology. Ann. WULS For. Wood Technol. 2023, 123, 109–117. [Google Scholar] [CrossRef]
- Lipska, K.; Goławski, S. Flax Pomace as a Substitute for Wood Raw Material in Lignocellulosiccomposite Technology. Ann. WULS For. Wood Technol. 2023, 123, 86–95. [Google Scholar] [CrossRef]
- Khedr, R.F.; Elnahas, H.H. Preparation of Wood Plastic Composite from Flax Fibers and Post Consumed Foam Based on Environmental and Economical Scales. J. Thermoplast. Compos. Mater. 2024, 37, 869–884. [Google Scholar] [CrossRef]
- Gursoy, M.; Sargin, I.; Mujtaba, M.; Akyuz, B.; Ilk, S.; Akyuz, L.; Kaya, M.; Cakmak, Y.S.; Salaberria, A.M.; Labidi, J.; et al. False Flax (Camelina Sativa) Seed Oil as Suitable Ingredient for the Enhancement of Physicochemical and Biological Properties of Chitosan Films. Int. J. Biol. Macromol. 2018, 114, 1224–1232. [Google Scholar] [CrossRef]
- Jeffrey, J.A.; Sivakumar, A.; Kumar, R.N.; Anbazhagan, A.; Manojkumar, G.; Al Obaid, S.; Alfarraj, S.; Sivakumar, S.; Rajkumar, S. Influence of Flax Fibre Hybridization on Mechanical Behaviour of Sisal Fibre-Polypropylene Composites Prepared with an Injection Moulding Machine. Adv. Mater. Sci. Eng. 2021, 2021, 4594465. [Google Scholar] [CrossRef]
- Van Thiem, Q.; Nguyen, V.-T.; Phan, D.T.T.; Minh, P.S. Injection Molding Condition Effects on the Mechanical Properties Of-Wood-Powder-Based Polymer Composite. Polymer 2024, 16, 1225. [Google Scholar] [CrossRef]
- Pradhan, S.K.; Dwarakadasa, E.S.; Reucroft, P.J. Processing and Characterization of Coconut Shell Powder Filled UHMWPE. Mater. Sci. Eng. A 2004, 367, 57–62. [Google Scholar] [CrossRef]
- Nadzri, S.N.I.H.A.; Sultan, M.T.H.; Shah, A.U.M.; Safri, S.N.A.; Talib, A.R.A.; Jawaid, M.; Basri, A.A. A Comprehensive Review of Coconut Shell Powder Composites: Preparation, Processing, and Characterization. J. Thermoplast. Compos. Mater. 2022, 35, 2641–2664. [Google Scholar] [CrossRef]
- Liminana, P.; Garcia-Sanoguera, D.; Quiles-Carrillo, L.; Balart, R.; Montanes, N. Development and Characterization of Environmentally Friendly Composites from Poly(Butylene Succinate) (PBS) and Almond Shell Flour with Different Compatibilizers. Compos. B Eng. 2018, 144, 153–162. [Google Scholar] [CrossRef]
- Ivorra-Martinez, J.; Manuel-Mañogil, J.; Boronat, T.; Sanchez-Nacher, L.; Balart, R.; Quiles-Carrillo, L. Development and Characterization of Sustainable Composites from Bacterial Polyester Poly(3-Hydroxybutyrate-Co-3-Hydroxyhexanoate) and Almond Shell Flour by Reactive Extrusion with Oligomers of Lactic Acid. Polymer 2020, 12, 1097. [Google Scholar] [CrossRef] [PubMed]
- Ramos, M.; Dominici, F.; Luzi, F.; Jiménez, A.; Garrigós, M.C.; Torre, L.; Puglia, D. Effect of Almond Shell Waste on Physicochemical Properties of Polyester-Based Biocomposites. Polymer 2020, 12, 835. [Google Scholar] [CrossRef] [PubMed]
- García, A.I.; García, A.M.; Bou, S.F. Study of the Influence of the Almond Shell Variety Onthe Mechanical Properties of Starch-Basedpolymer Biocomposites. Polymer 2020, 12, 2049. [Google Scholar] [CrossRef]
- Ferrer, A.; Salas, C.; Rojas, O.J. Physical, Thermal, Chemical and Rheological Characterization of Cellulosic Microfibrils and Microparticles Produced from Soybean Hulls. Ind. Crops Prod. 2016, 84, 337–343. [Google Scholar] [CrossRef]
- Balla, V.K.; Tadimeti, J.G.D.; Kate, K.H.; Satyavolu, J. 3D Printing of Modified Soybean Hull Fiber/Polymer Composites. Mater. Chem. Phys. 2020, 254, 123452. [Google Scholar] [CrossRef]
- Nanda, M.R.; Misra, M.; Mohanty, A.K. Mechanical Performance of Soy-Hull-Reinforced Bioplastic Green Composites: A Comparison with Polypropylene Composites. Macromol. Mater. Eng. 2012, 297, 184–194. [Google Scholar] [CrossRef]
- Sivakumar, A.; Srividhya, S.; Prakash, R.; Subbarayan, M.R. Exploring the Effects of Eco-Friendly and Biodegradable Biocomposite with PLA Incorporating Eggshell and Walnut Powder as Fillers. Glob. Nest J. 2024, 26, 1–6. [Google Scholar] [CrossRef]
- Chaturvedi, A.; Ranakoti, L.; Rakesh, P.K.; Mishra, N.K. Experimental Investigations on Mechanical Properties of Walnut Shell And Pine Needle Ash Polylactic Acid Biocomposites. Compos. Theory Pract. 2021, 21, 114–120. [Google Scholar]
- Karagöz, İ. Production and Characterization of Sustainable Biocompatible PLA/Walnut Shell Composite Materials. Polym. Bull. 2024, 81, 11517–11537. [Google Scholar] [CrossRef]
- Orue, A.; Eceiza, A.; Arbelaiz, A. The Use of Alkali Treated Walnut Shells as Filler in Plasticized Poly(Lactic Acid) Matrix Composites. Ind. Crops Prod. 2020, 145, 111993. [Google Scholar] [CrossRef]
- Song, X.; Guan, W.; Qin, H.; Han, X.; Wu, L.; Ye, Y. Properties of Poly(Lactic Acid)/Walnut Shell/Hydroxyapatite Composites Prepared with Fused Deposition Modeling. Sci. Rep. 2022, 12, 11563. [Google Scholar] [CrossRef] [PubMed]
- Betlej, I.; Borysiuk, P.; Borysiak, S.; Rybak, K.; Nowacka, M.; Barlak, M.; Andres, B.; Krajewski, K.; Lipska, K.; Cebulak, T.; et al. Pomace from Oil Plants as a New Type of Raw Material for the Production of Environmentally Friendly Biocomposites. Coatings 2023, 13, 1722. [Google Scholar] [CrossRef]
- EN 323:1999; Wood-Based Panels—Determination of Density. ISO: Geneva, Switzerland, 1999.
- EN 310:1994; Wood-Based Panels—Determination of Modulus of Elasticity in Bending and of Bending Strength. ISO: Geneva, Switzerlan, 1994.
- EN ISO 21920-2:2022-06; Product Geometry Specifications (GPS)—Geometric Structure of Surfaces: Profile—Part 2: Terms, Definitions and Parameters of Geometric Structure of Surfaces. ISO: Geneva, Switzerlan, 2022.
- EN 317:1999; Particleboards and Fiberboards—Determination of Swelling to Thickness after Immersion in Water. European Committee for Standardization: Brussels, Belgium, 1999.
- FTIR Functional Group Database Table with Search—InstaNANO. Available online: https://instanano.com/all/characterization/ftir/ftir-functional-group-search/ (accessed on 30 June 2024).
- Stokke, D.D.; Wu, Q.; Han, G. Introduction to Wood and Natural Fiber Composites; Wiley Series in Renewable Resources; John Wiley & Sons: Hoboken, NJ, USA, 2013. [Google Scholar]
- Patsiaoura, D.; Tarani, E.; Bikiaris, D.N.; Pavlidou, E.; Chrissafis, K. Lignocellulosic-Based/High Density Polyethylene Composites: A Comprehensive Study on Fiber Characteristics and Performance Evaluation. Appl. Sci. 2024, 14, 3582. [Google Scholar] [CrossRef]
- Meekum, U. Manufacturing of Wood Plastic Composite from Polyethylene/Poly(Ethylene Terephthalate) Waste/Ultra High Molecular Weight Polyethylene Blends and Rice Husk Fiber: Raw Materials Preparation and Preliminary Processing Investigation. Bioresources 2023, 18, 1293–1329. [Google Scholar] [CrossRef]
- Khan, A.; Mishra, A.; Patidar, R.; Pappu, A. Effect of Lignocellulosic Corn Stalk on Mechanical, Physical, and Thermal Properties of Injection Moulded Low Density Polyethylene Composites: An Approach towards a Circular Economy. Heliyon 2024, 10, e25287. [Google Scholar] [CrossRef]
- Hasanin, M.S.; Abd El-Aziz, M.E.; El-Nagar, I.; Hassan, Y.R.; Youssef, A.M. Green Enhancement of Wood Plastic Composite Based on Agriculture Wastes Compatibility via Fungal Enzymes. Sci. Rep. 2022, 12, 19197. [Google Scholar] [CrossRef]
- Berger, C.; Mattos, B.D.; Amico, S.C.; Antonio De Farias, J.; Coldebella, R.; Gatto, D.A.; Missio, A.L. Production of Sustainable Polymeric Composites Using Grape Pomace Biomass. Biomass Convers. Biorefinery 2022, 12, 5869–5880. [Google Scholar] [CrossRef]
- Mishra, M.; Duan, B. The Essential Handbook of Polymer Terms and Attributes; CRC Press: Boca Raton, FL, USA, 2024. [Google Scholar]
- Smith, B.C. Infrared Spectral Interpretation: A Systematic Approach; CRC Press: Boca Raton, FL, USA, 1998; ISBN 0849324637. [Google Scholar]
- Gulmine, J.V.; Janissek, P.R.; Heise, H.M.; Akcelrud, L. Polyethylene Characterization by FTIR. Polym. Test. 2002, 21, 557–563. [Google Scholar] [CrossRef]
- Smith, B.C. The Infrared Spectra of Polymers II: Polyethylene. Spectroscopy 2021, 36, 24–29. [Google Scholar] [CrossRef]
- Fernandes, E.M.; Mano, J.F.; Reis, R.L. Polyethylene Composites with Lignocellulosic Material. In Polyethylene-Based Blends, Composites and Nanocomposites; John Wiley & Sons: Hoboken, NJ, USA, 2015; pp. 117–161. [Google Scholar]
- Patel, A.R. (Ed.) Edible Oil Structuring: Concepts, Methods and Applications; The Royal Society of Chemistry: London, UK, 2017; ISBN 978-1-78262-829-3. [Google Scholar]
- Kaur, K.; Kaur, R.; Kaur, H. A Systematic Review of Lignocellulosic Biomass for Remediation of Environmental Pollutants. Appl. Surf. Sci. Adv. 2024, 19, 100547. [Google Scholar] [CrossRef]
- Yuzhen, L.; Changwen, D.; Yanqiu, S.; Jianmin, Z. Characterization of Rapeseed Oil Using FTIR-ATR Spectroscopy. J. Food Sci. Eng. 2014, 4, 244–249. [Google Scholar] [CrossRef]
- Radu, M.C.; Tampu, R.; Nedeff, V.; Patriciu, O.I.; Schnakovszky, C.; Herghelegiu, E. Experimental Investigation of Stability of Vegetable Oils Used as Dielectric Fluids for Electrical Discharge Machining. Processes 2020, 8, 1187. [Google Scholar] [CrossRef]
- Agatonovic-Kustrin, S.; Ristivojevic, P.; Gegechkori, V.; Litvinova, T.M.; Morton, D.W. Essential Oil Quality and Purity Evaluation via Ft-Ir Spectroscopy and Pattern Recognition Techniques. Appl. Sci. 2020, 10, 7294. [Google Scholar] [CrossRef]
- Kondo, T. The Assignment of IR Absorption Bands Due to Free Hydroxyl Groups in Cellulose. Cellulose 1997, 4, 281–292. [Google Scholar] [CrossRef]
- Hospodarova, V.; Singovszka, E.; Stevulova, N.; Hospodarova, V.; Singovszka, E.; Stevulova, N. Characterization of Cellulosic Fibers by FTIR Spectroscopy for Their Further Implementation to Building Materials. Am. J. Anal. Chem. 2018, 9, 303–310. [Google Scholar] [CrossRef]
- Bruun, S.W.; Kohler, A.; Adt, I.; Sockalingum, G.D.; Manfait, M.; Martens, H. Correcting Attenuated Total Reflection-Fourier Transform Infrared Spectra for Water Vapor and Carbon Dioxide. Appl. Spectrosc. 2006, 60, 1029–1039. [Google Scholar] [CrossRef]
- Bakhattar, I.; Asbik, M.; Koukouch, A.; Aadnan, I.; Zegaoui, O.; Belandria, V.; Bonnamy, S.; Sarh, B. Physicochemical Characterization, Thermal Analysis and Pyrolysis Kinetics of Lignocellulosic Biomasses. Biofuels 2023, 14, 1015–1026. [Google Scholar] [CrossRef]
- Zhang, H.; Ma, J.; Miao, Y.; Tuchiya, T.; Chen, J.Y. Analysis of Carbonyl Value of Frying Oil by Fourier Transform Infrared Spectroscopy. J. Oleo Sci. 2015, 64, 375–380. [Google Scholar] [CrossRef] [PubMed]
- Kotilainen, R.A.; Toivanen, T.J.; Alén, R.J. FTIR Monitoring of Chemical Changes in Softwood during Heating. J. Wood Chem. Technol. 2000, 20, 307–320. [Google Scholar] [CrossRef]
- Apaydın Varol, E.; Mutlu, Ü. TGA-FTIR Analysis of Biomass Samples Based on the Thermal Decomposition Behavior of Hemicellulose, Cellulose, and Lignin. Energies 2023, 16, 3674. [Google Scholar] [CrossRef]
- Sikora, A.; Kačík, F.; Gaff, M.; Vondrová, V.; Bubeníková, T.; Kubovský, I. Impact of Thermal Modification on Color and Chemical Changes of Spruce and Oak Wood. J. Wood Sci. 2018, 64, 406–416. [Google Scholar] [CrossRef]
- Windeisen, E.; Wegener, G. Behaviour of Lignin during Thermal Treatments of Wood. Ind. Crops Prod. 2008, 27, 157–162. [Google Scholar] [CrossRef]
- Liu, Y.; Hu, T.; Wu, Z.; Zeng, G.; Huang, D.; Shen, Y.; He, X.; Lai, M.; He, Y. Study on Biodegradation Process of Lignin by FTIR and DSC. Environ. Sci. Pollut. Res. 2014, 21, 14004–14013. [Google Scholar] [CrossRef]
- Hao, Y.; Pan, Y.; Du, R.; Wang, Y.; Chen, Z.; Zhang, X.; Wang, X. The Influence of a Thermal Treatment on the Decay Resistance of Wood via FTIR Analysis. Adv. Mater. Sci. Eng. 2018, 2018, 8461407. [Google Scholar] [CrossRef]
- Reyes-Rivera, J.; Terrazas, T. Lignin Analysis by HPLC and FTIR. In Methods in Molecular Biology; Humana Press Inc.: Totowa, NJ, USA, 2017; Volume 1544, pp. 193–299. [Google Scholar]

| Variant | Average Density [kg/m3] | Coefficient of Variation [%] |
|---|---|---|
| PE_0 | 897 | 1 |
| PE_EP | 984 | 7 |
| PE_G | 921 | 13 |
| PE_R | 918 | 10 |
| PE_S | 906 | 12 |
Disclaimer/Publisher’s Note: The statements, opinions and data contained in all publications are solely those of the individual author(s) and contributor(s) and not of MDPI and/or the editor(s). MDPI and/or the editor(s) disclaim responsibility for any injury to people or property resulting from any ideas, methods, instructions or products referred to in the content. |
© 2024 by the authors. Licensee MDPI, Basel, Switzerland. This article is an open access article distributed under the terms and conditions of the Creative Commons Attribution (CC BY) license (https://creativecommons.org/licenses/by/4.0/).
Share and Cite
Lipska, K.; Betlej, I.; Rybak, K.; Nowacka, M.; Boruszewski, P. Oil Plant Pomace as a Raw Material in Technology of Sustainable Thermoplastic Polymer Composites. Sustainability 2024, 16, 7088. https://doi.org/10.3390/su16167088
Lipska K, Betlej I, Rybak K, Nowacka M, Boruszewski P. Oil Plant Pomace as a Raw Material in Technology of Sustainable Thermoplastic Polymer Composites. Sustainability. 2024; 16(16):7088. https://doi.org/10.3390/su16167088
Chicago/Turabian StyleLipska, Karolina, Izabela Betlej, Katarzyna Rybak, Małgorzata Nowacka, and Piotr Boruszewski. 2024. "Oil Plant Pomace as a Raw Material in Technology of Sustainable Thermoplastic Polymer Composites" Sustainability 16, no. 16: 7088. https://doi.org/10.3390/su16167088
APA StyleLipska, K., Betlej, I., Rybak, K., Nowacka, M., & Boruszewski, P. (2024). Oil Plant Pomace as a Raw Material in Technology of Sustainable Thermoplastic Polymer Composites. Sustainability, 16(16), 7088. https://doi.org/10.3390/su16167088

